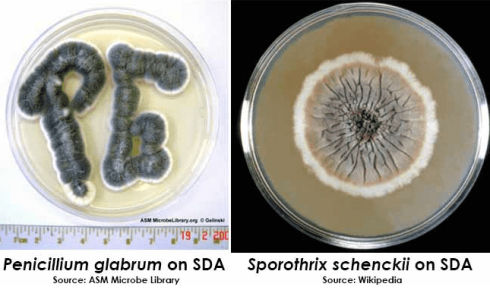
مورفولوژی کلنی در SDA

سابورو دکستروز آگار (SDA) برای جداسازی، کشت و نگهداری گونههای غیر بیماریزا و بیماریزای قارچها و مخمرها استفاده میشود. SDA توسط Sabouraud در سال 1892 برای کشت درماتوفیت ها فرموله شد. pH به منظور افزایش رشد قارچها، بهویژه درماتوفیتها و مهار رشد باکتریها در نمونههای بالینی، تقریباً به میزان ۵.۶ تنظیم میشود.
ترکیبات سابورو دکستروز آگار
- دکستروز (گلوکز): 40 گرم/ لیتر
- پپتون: 10 گرم/ لیتر
- آگار: 15گرم/ لیتر
- آب مقطر: 1000 میلیلیتر
pH نهایی: ۵٫۶ +/- ۰٫۲ در ۲۵ درجه سانتیگراد.
به علاوه لازم به ذکر است:
براث سابورو دکستروز همان فرمول فوق ، البته بدون افزودن آگار است.
pH نهایی آن ۵٫۶ +/- ۰٫۲ در ۲۵ درجه سانتیگراد است.
سابورو دکستروز آگار با کلرامفنیکل، حاوی ۵۰٫۰ میلیگرم کلرامفنیکل است.
pH نهایی ۵٫۶ +/- ۰٫۳ در ۲۵ درجه سانتیگراد است.
سابورو دکستروز آگار با کلرامفنیکل و جنتامایسین حاوی ۵۰٫۰ میلیگرم کلرامفنیکل و ۵٫۰ میلیگرم جنتامایسین است.
pH نهایی ۵٫۶ +/- ۰٫۳ در ۲۵ درجه سانتیگراد است.
سابورو دکستروز آگار با کلرامفنیکل و تتراسایکلین حاوی ۵۰٫۰ میلیگرم کلرامفنیکل و ۱۰٫۰ میلیگرم تتراسایکلین است.
pH نهایی ۵٫۶ +/- ۰٫۳ در ۲۵ درجه سانتیگراد است.
سابورو دکستروز آگار امونس تنها 20.0 گرم دکستروز دارد.
pH نهایی ۶٫۹ +/- ۰٫۲ در ۲۵ درجه سانتیگراد است.
اساس آگار SDA
پپتون (هضم آنزیمی کازئین و هضم آنزیمی بافت حیوانی) منبع نیتروژن و ویتامین مورد نیاز برای رشد ارگانیسم در SDA را فراهم میکند. دکستروز به عنوان منبع انرژی و کربن اضافه میشود. آگار عامل انسجام و شکل گیری است.
کلرامفنیکل و/یا تتراسایکلین ممکن است به عنوان مواد ضد میکروبی با طیف وسیع برای مهار رشد طیف وسیعی از باکتریهای گرم مثبت و گرم منفی اضافه شوند. جنتامایسین برای مهار بیشتر رشد باکتریهای گرم منفی اضافه میشود.
به نظر میرسد PH خنثی در امونس (Emmons)، رشد برخی از قارچهای بیماریزا مانند درماتوفیت ها را افزایش میدهد.
موارد استفاده از SDA
- SDA در درجه اول برای کشت انتخابی مخمرها، کپکها و باکتریهای اسیدی استفاده میشود.
- این محیط اغلب همراه با آنتیبیوتیکها برای جداسازی قارچهای بیماریزا از مواد حاوی تعداد زیادی قارچ یا باکتری دیگر استفاده میشود.
- این محیط همچنین برای تعیین آلودگی میکروبی در مواد غذایی، آرایشی و بهداشتی و نمونههای بالینی استفاده میشود.

تهیه سابورو دکستروز آگار
- همه مواد را در ۹۰۰ میلیلیتر آب دیونیزه ترکیب کنید.
- PH را با اسید هیدروکلریک روی ۵٫۶ تنظیم کنید و حجم نهایی را روی ۱ لیتر تنظیم کنید.
- ترکیب را حرارت دهید تا به جوش آید و محیط کاملاً محلول شود.
- محلول را در دمای ۱۲۱ درجه سانتیگراد به مدت ۱۵ دقیقه اتوکلاو کنید.
- در دمای ۴۵ تا ۵۰ درجه سانتیگراد خنک کنید و در پتری دیش یا لولههای آزمایش به صورت مایل بریزید.
پلیتهای سابورو آگار را میتوان با تلقیح رگهای، مانند محیطهای باکتریولوژیکی استاندارد، یا با قرار دادن محیط کشت در معرض هوای محیط تلقیح کرد. به طور معمول، کپکها در دمای اتاق (۲۲ تا ۲۵ درجه سانتیگراد) و مخمرها در دمای ۲۸ تا ۳۰ درجه سانتیگراد یا ۳۷ درجه سانتیگراد در صورت مشکوک بودن به قارچهای دوگانه انکوبه میشوند.
زمان انکوباسیون متفاوت است، از تقریباً ۲ روز برای رشد کلنیهای مخمر مانند مالاسزیا، تا ۲ تا ۴ هفته برای رشد درماتوفیتها یا قارچهای دوگانه مانند هیستوپلاسما کپسولاتوم. در واقع، زمان انکوباسیون مورد نیاز برای رشد قارچ یکی از شاخصهای تشخیصی است که برای شناسایی یا تأیید گونههای قارچی استفاده میشود.
تفسیر نتایج در آگار SDA
شناسایی قارچها با مشاهده جنبههای مختلف مورفولوژی کلنی، ساختارهای میکروسکوپی مشخص، سرعت رشد، محیط حمایت کننده از رشد ارگانیسم و منبع نمونه انجام میشود. مخمرها با آزمایشهای مختلف بیوشیمیایی شناسایی میشوند.
مخمرها به صورت کلنیهای کرم (خامهای) تا سفید رشد خواهند کرد. کپکها به صورت کلنیهای رشتهای با رنگهای مختلف رشد خواهند کرد.
مورفولوژی کلنی در SDA

کنترل کیفیت SDA
ظاهر
محیط کم آب: پودر به رنگ کاه و با جریان آزاد (free-flowing powder)
محیط آماده شده: ژل با رنگ کاهی تا کاهی روشن

محدودیتهای سابورو دکستروز آگار
- ممکن است با برخی از سویهها مواجه شوید که رشد ضعیفی دارند یا در این محیط رشد نمیکنند.
- عوامل ضد میکروبی اضافه شده به محیط برای مهار باکتریها، ممکن است برخی از قارچهای بیماریزا را نیز مهار کنند.
- از گرم کردن بیش از حد یک محیط کشت با pH اسیدی خودداری کنید، این کار ممکن است باعث ایجاد یک محیط کشت نرم شود.
- برای شناسایی و تشخیص، ارگانیسمها باید در محیط کشت خالص باشند.
- برای شناسایی نهایی، آزمایشات مورفولوژیکی، بیوشیمیایی و یا سرولوژیکی باید انجام شود.
- این محیط کشت باعث تقویت قارچهای رشتهای نمیشود.
جهت خرید و یا استعلام قیمت با ما تماس بگیرید یا در واتسپ پیام بزارید
همچنین بخوانید:
- آگار SCA (نشاسته کازئین آگار): ترکیب، کاربردها، آماده سازی و تفسیر
- آگار ستریماید (Cetrimide Agar): ترکیب، اساس، کاربردها، آماده سازی و مورفولوژی کلنی
مترجم: مریم محجوب



